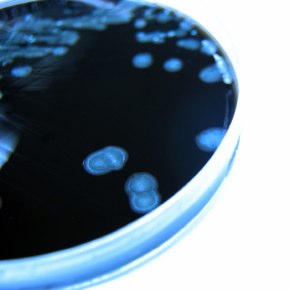

PIBULJ
Fair Compensation? - Steven Weddle, Hardwicke

06/09/12. Until the Lord Chancellor started to fix the discount rate for calculating future loss multipliers the Courts did their best to provide a "real" rate by looking at reality. In so doing they were trying their best to provide fair and proper compensation. In setting the rate at 2.5% in 2001 the then Lord Chancellor set it higher than the actual return rate at that time and save for one or two months it has now been too low for nearly 11 years. An attempt at judicial review to try and force a change was rejected in 2011 on the basis that...
Image ©iStockphoto.com/DNY59
Read more (PIBULJ subscribers only)...
Update on Gastric Illness Claims - Andrew Young, 3 Hare Court
06/09/12. In a recent landmark decision at first instance, a trial judge decided that the law imposes strict liability on tour operators in respect of food poisoning claims brought by purchasers of all-inclusive package holidays. The case of Antcliffe v. Thomas Cook Tour Operations Ltd (4.7.2012, unreported, HHJ Worster, Birmingham County Court) concerned a family who went on an all-inclusive holiday to the Dominican Republic arranged by the Defendant as tour operator. In the course of the holiday, all five members of the family fell ill with gastroenteritis (although only three brought claims). Under the Package Travel Etc Regulations 1992, the Defendant as tour operator is...
Image ©iStockphoto.com/Linde1
Read more (PIBULJ subscribers only)...
Relief from sanctions: the trend every litigator needs to know about - Sarah Prager, 1 Chancery Lane

05/09/12. Sarah Prager discusses a growing trend for judges in the higher and lower courts to refuse to grant relief from sanctions; and asks where we go from here. Sooner or later all litigators have cause to familiarise themselves with the provisions of CPR Part 3.9, which reads:
“3.9 Relief from sanctions
(1) On an application for relief from any sanction imposed for a failure to comply with any rule, practice direction or court order the court will consider all the circumstances including:
(a) the interests of the administration of justice...
Image ©iStockphoto.com/spxChrome
Read more (PIBULJ subscribers only)...
Abuse of Process - Michael Brace, Barrister at Civitas Law

03/09/12. With an ever increasing focus on claimant abuse of the claims process, Michael Brace, Barrister at Civitas Law analyses the power to strike out fraudulent claims at trial. In Fairclough Homes Ltd v Summers [2012] UKSC, the Respondent suffered serious hand and leg fractures in an accident at work in May 2003. In August 2007 the county court entered judgement for the...
Image ©iStockphoto.com/Vii-Studio
Read more (PIBULJ subscribers only)...
Writing for PI Brief Update Law Journal
About PIBULJ
Personal Injury Brief Update Law Journal (PIBULJ) is the leading online PI law journal in the UK. It has been running since 2006. Subscribers get access to over 600 personal injury articles and we publish around 25 new articles per month. The articles are written mostly by barristers and solicitors. Click the links below for further details about the journal:
The currently featured homepage articles
A list of past monthly issues with contents
More information about ourselves
Benefits of Writing for PIBULJ
The article titles, summaries and author names are publicly accessible on this website (for non-subscribers and Google searches) and are also emailed twice per month in our newsletters to a database of 13,000 email addresses. The readers are solicitors and other professionals in the UK personal injury industry. The author profiles also appear on our contributors page. The full article texts are accessible by subscribing firms who are mostly solicitors offices.
How to Contribute
If you'd like to write an article, simply email it to This email address is being protected from spambots. You need JavaScript enabled to view it. . We can handle nearly all formats, though most writers prefer to use Microsoft Word.
Articles can be however short or long you choose from as little as a couple of hundred words up to several thousand.
If you have any questions at all or would like to chat about it or indeed if you have any ideas for articles, please don't hesitate to get in contact.











![Appeal judge rules that credit hire company has no costs liability following a finding of fundamental dishonesty in personal injury case: RSA v. Fastrack Solutions Limited [2023] 4 WLUK 92 - David Bowden, Erimus Chambers](/content/images/resized/images/stories/carkeys_72_72.jpg)


